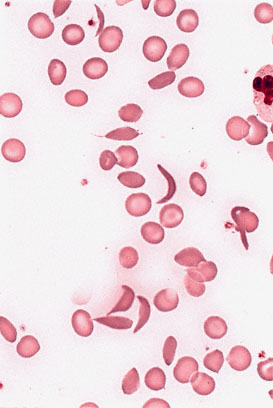

NBME 33 – Block 4
Time limit: 0
Quiz Summary
0 of 20 Questions completed
Questions:
Information
You have already completed the quiz before. Hence you can not start it again.
Quiz is loading…
You must sign in or sign up to start the quiz.
You must first complete the following:
Results
Quiz complete. Results are being recorded.
Results
0 of 20 Questions answered correctly
Your time:
Time has elapsed
You have reached 0 of 0 point(s), (0)
Earned Point(s): 0 of 0, (0)
0 Essay(s) Pending (Possible Point(s): 0)
Categories
- Not categorized 0%
- 1
- 2
- 3
- 4
- 5
- 6
- 7
- 8
- 9
- 10
- 11
- 12
- 13
- 14
- 15
- 16
- 17
- 18
- 19
- 20
- Current
- Review
- Answered
- Correct
- Incorrect
-
Question 1 of 20
1. Question
A 37-year-old woman comes to the physician because of a 6-week history of pain and swelling of her hands, wrists, and knees. Physical examination shows swelling, warmth, and tenderness of several metacarpal, phalangeal, and proximal interphalangeal joints bilaterally and of the wrists and knees. Serum studies show rheumatoid factor and anticyclic citrullinated polypeptide antibodies. Administration of prednisone results in clinical improvement. Which of the following is the most likely mechanism of the beneficial effect of this drug in this patient?
CorrectIncorrect -
Question 2 of 20
2. Question

An 18-year-old man has recurrent hematuria and a serum creatinine concentration of 1.2 mg/dL. Results of immunofluorescence studies for immunoglobulin heavy chains of a glomerulus are shown. Which of the following is the most likely diagnosis?
CorrectIncorrect -
Question 3 of 20
3. Question
A 40-year-old man who lives in Rhode Island comes to the physician because of intermittent fever and marked fatigue over the past 6 months. He is a frequent hunter and has had numerous tick bites on recent hunting trips. He had a splenectomy at age 15 years after an automobile collision; he received numerous blood transfusions during that hospitalization. His temperature now is 37°C (98.6°F), pulse is 84/min, respirations are 20/min, and blood pressure is 130/80 mm Hg. Physical examination shows mild jaundice and an evanescent, slightly erythematous, and pruritic rash. The liver is tender and palpated 6 cm below the right costal margin. Serum transaminase activities are increased. A peripheral blood smear shows schistocytes and numerous ring-like structures within erythrocytes, several of which show tetrad formations. Which of the following is the most likely causal organism?
CorrectIncorrect -
Question 4 of 20
4. Question
The mother of a 13-year-old boy calls the physician to seek advice. She says, “I just caught my son smoking. I am so upset. Since he’s been able to talk, I’ve told him over and over again that smoking is bad. When he was 7 years old, he would even embarrass me in restaurants complaining about other people smoking. No one has ever smoked in our house. Now he’s doing it. I’ve tried to talk to him and he just won’t answer me. What can I do to make him stop?” When advising the mother on how to get her son to stop smoking, which of the following actions on her part will have the greatest impact?
CorrectIncorrect -
Question 5 of 20
5. Question
A 35-year-old primigravid woman at 17 weeks’ gestation comes to the office because of a 3-week history of mild pain in her arms and hands. The pain increases in severity with physical activity and keeps her awake at night. She notes mild weakness when gripping small objects. Pregnancy has been uncomplicated. She has no history of serious illness, and her only medication is a prenatal vitamin. Physical examination shows a uterus consistent in size with a 17-week gestation. Which of the following additional physical findings is most likely in this patient?
CorrectIncorrect -
Question 6 of 20
6. Question
A 27-year-old woman at 12 weeks’ gestation comes to the physician because of a 3-day history of weakness and fatigue. She has hypertension treated with methyldopa for the past year. Her blood pressure today is 120/70 mm Hg. Physical examination shows pallor and a uterus consistent in size with a 12-week gestation. Laboratory studies show a hemoglobin concentration of 9 g/dL, hematocrit of 40%, reticulocyte count of 15%, and spherocytosis. A direct antiglobulin (Coombs) test result is positive. Which of the following is the most likely cause of the anemia in this patient?
CorrectIncorrect -
Question 7 of 20
7. Question
A 25-year-old man comes to the physician because of thickening of his skin, diarrhea, and weight loss during the past 6 months. Physical examination shows generalized hyperkeratotic skin lesions. Serum concentrations of antiendomysial and anti-tissue transglutaminase antibodies are increased. Stool analysis shows an increased fat concentration. Which of the following is the most likely mechanism of the deficiency causing this patient’s skin lesions?
CorrectIncorrect -
Question 8 of 20
8. Question

A 58-year-old woman comes to the physician because of a 6-month history of fatigue and muscle weakness. Physical examination shows no abnormalities. Serum studies show a calcium concentration of 11.8 mg/dL and intact parathyroid hormone concentration of 340 pg/mL. A nuclear parathyroid scan is shown; the arrow indicates a parathyroid adenoma in the region of the right lower pole of the thyroid gland. This adenoma is most likely located in which of the following labeled areas of the axial CT scan of the thyroid gland?
 CorrectIncorrect
CorrectIncorrect -
Question 9 of 20
9. Question
A 13-year-old girl is brought to the physician because of a 2-week history of fever, sore throat, palpitations, and intermittent pain and swelling of multiple joints. She does not appear to be in acute distress. Her temperature is 38.3°C (100.9°F), pulse is 110/min, respirations are 16/min, and blood pressure is 126/84 mm Hg. Physical examination shows a pericardial friction rub, a grade 2/6 holosystolic murmur, and redness and swelling of the left knee. Laboratory studies show an increased erythrocyte sedimentation rate and antistreptolysin O antibodies. A throat culture grows no organisms. A chest x-ray shows cardiomegaly. Echocardiography shows multiple 0.3-cm vegetations on the mitral valve. Which of the following best describes the pathogenesis of the valvular heart disease in this patient?
CorrectIncorrect -
Question 10 of 20
10. Question
A 35-year-old man is brought to the emergency department 1 hour after the police found him collapsed and unresponsive in an alleyway. He is known to have alcohol use disorder and use intravenous illicit drugs. Physical examination shows jaundice and multiple widespread cutaneous ecchymoses. Laboratory studies show a platelet count of 160,000/mm3, prothrombin time of 20 seconds (INR=3), and partial thromboplastin time of 55 seconds. Test of the stool for occult blood is positive. Which of the following steps in procoagulant protein synthesis is most likely defective in this patient?
CorrectIncorrect -
Question 11 of 20
11. Question
A 47-year-old man is diagnosed with acute myelogenous leukemia. He has no personal or family history of major medical illness. He has never smoked. He has worked at a local oil refinery for the past 20 years. The patient believes that his leukemia was caused by exposure to chemicals at his job. He tells the physician, “If you write a letter to my employer stating that my illness was caused by something I was exposed to at my job, then workers’ compensation will pay for my treatment and provide me with some income to help care for my family. Can you help me?” Which of the following is the most appropriate initial response by the physician?
CorrectIncorrect -
Question 12 of 20
12. Question
A 4-year-old boy is brought to a clinic in Thailand because of a 6-hour history of profuse diarrhea. His mother says that their only source of water is a stream. His temperature is 37°C (98.6°F), pulse is 120/min, respirations are 28/min, and palpable systolic blood pressure is 60 mm Hg. Physical examination shows severe volume depletion. Fresh stool analysis shows motile, curved, gram-negative rods with flagella. Which of the following best describes the mechanism of action of the toxin of the causal organism?
CorrectIncorrect -
Question 13 of 20
13. Question
A 21-year-old man is brought to the emergency department 30 minutes after fainting while playing basketball. There was no trauma or evidence of seizure activity when he fainted. He has a history of a benign, low-grade cardiac murmur that had been attributed to his fitness as an athlete. He is now conscious. His temperature is 37.6°C (99.6°F), pulse is 62/min, respirations are 12/min, and blood pressure is 122/70 mm Hg. There is no cyanosis. The lungs are clear. Cardiac examination shows a double impulse over the carotid arteries. There are normal pulses in the extremities. S1 and S2 are normal, but there is a grade 3/6, systolic ejection murmur heard best in the second intercostal space at the left parasternal border and into the apex. The murmur increases in intensity on Valsalva maneuver. Which of the following is the most likely cause of this patient’s murmur?
CorrectIncorrect -
Question 14 of 20
14. Question
A 65-year-old man has a 7-month history of fatigue and abdominal discomfort. Examination shows splenomegaly and hepatomegaly. A complete blood count shows anemia, teardrop erythrocytes, and a leukoerythroblastic reaction. A bone marrow biopsy shows myelofibrosis. Which of the following findings is most likely to be seen on microscopic examination of tissue from the spleen?
CorrectIncorrect -
Question 15 of 20
15. Question
A 28-year-old woman comes to the physician because of insomnia since her fiancé suddenly broke off their engagement 10 days ago. She has difficulty falling asleep, but once she is asleep she usually sleeps well. Taking hot baths, drinking chamomile tea, and listening to soothing music before bed have not resulted in relief. She states that her lack of sleep is beginning to affect her performance at work, and she asks for medication to help her temporarily. If the physician determines that pharmacotherapy to help this patient sleep is indicated, the most appropriate medication has which of the following mechanisms of action?
CorrectIncorrect -
Question 16 of 20
16. Question
A 22-year-old man comes to the emergency department 30 minutes after his left forearm was slashed with a pocketknife during a bar fight. Continuous application of pressure to the affected area has not resolved the profuse bleeding. His pulse is 140/min, and blood pressure is 100/65 mm Hg. Physical examination shows pale conjunctivae. Examination of the left upper extremity shows a 3-cm laceration that is oriented transversely over the palmar aspect of the distal forearm and located 2 cm proximal to the distal palmar wrist crease. He is unable to abduct the left thumb or flex the metacarpophalangeal or proximal interphalangeal joints of the index and middle fingers. He is able to flex the distal interphalangeal joints of all digits, including the thumb. Sensation to pinprick is decreased over the palmar aspect of the thumb and index and middle fingers. Capillary refill time is normal for all digits. Doppler pulse evaluation of the superficial palmar arch shows an intact signal. A median nerve injury is suspected. Which of the following tendons also is most likely injured in this patient?
CorrectIncorrect -
Question 17 of 20
17. Question
A 35-year-old woman comes to the physician for a follow-up examination. Three months ago she underwent operative removal of a catecholamine-secreting tumor from the right adrenal gland. Her mother has retinal angiomas and her maternal grandfather had a hemangioblastoma of the cerebellum. Physical examination shows a well-healed laparoscopic scar on the abdomen. This patient most likely has a mutation of which of the following genes?
CorrectIncorrect -
Question 18 of 20
18. Question
A 32-year-old man comes to the physician because of a 2-month history of intermittent diarrhea and nausea without vomiting. The symptoms occur in the mornings before work and sometimes cause him to be late or stay home. The diarrhea is brown and loose with no traces of blood. The symptoms subside on the weekends. Physical examination shows no abnormalities. Which of the following questions by the physician is most likely to be helpful in establishing the diagnosis?
CorrectIncorrect -
Question 19 of 20
19. Question
A 10-year-old African American boy is brought to the emergency department because of a 4-hour history of severe abdominal pain. He appears in acute distress. Physical examination shows pale mucous membranes. Bowel sounds are normal, and there is no rebound tenderness. His hemoglobin concentration is 8 g/dL and hematocrit is 25%. A photomicrograph of a peripheral blood smear is shown. Which of the following hemoglobin abnormalities is the most likely cause of the findings in this patient?
CorrectIncorrect -
Question 20 of 20
20. Question
A 36-year-old woman comes to the office because of a 1-year history of progressive fatigue and weakness as well as decreased appetite and intermittent nausea. She also has had a 5-kg (11-lb) weight loss during this time. Vital signs are within normal limits. Physical examination shows no abnormalities. Results of laboratory studies are shown:
Hemoglobin
11.6 g/dL
Hematocrit
34%
Serum
Na+
132 mEq/L
K+
5.7 mEq/L
Glucose [fasting]
55 mg/dL
Adrenocorticotropic hormone
300 pg/mL (N<120)
Which of the following histopathologic changes is most likely in this patient’s adrenal cortex?
CorrectIncorrect
